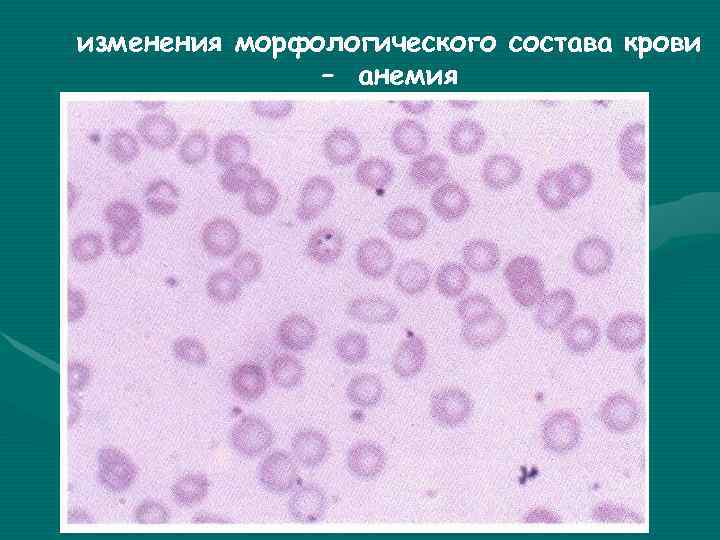
изменения морфологического состава крови – анемия изменения морфологического состава крови – анемия

ЛУЧЕВЫЕ РЕАКЦИИ И ОСЛОЖНЕНИЯ Модуль №

pr_reaktsii_i_osl.ppt
- Количество слайдов: 29
ЛУЧЕВЫЕ РЕАКЦИИ И ОСЛОЖНЕНИЯ Модуль № 1 Кафедра радиологии и радиационной медицины
ЛУЧЕВЫЕ РЕАКЦИИ • Лучевая терапия злокачественных опухолей сопровождается общими и местными лучевыми реакциями. • Лучевые реакции – это изменения, которые возникают в органах и тканях на фоне облучения или через 2 – 3 недели по окончании лечения и, как правило, проходят самостоятельно. • Лучевые реакции разделяются на общие и ме
ЛУЧЕВЫЕ РЕАКЦИИ • МЕСТНЫЕ • ОБЩИЕ реакции, которые Реакции, которые возникают в месте возникают после действия облучения на ионизирующего уровне всего излучения. организма.
МЕСТНЫЕ РЕАЦИИ реакции, которые возникают в месте действия ионизирующего излучения. Это: • изменения на коже (эритема, сухой и влажный дерматиты); • изменения слизистых оболочек (отек и гиперемия, ороговение, десквамация эпителия, пленочный и сливной радиоепителиит, эрозии); • изменения внутренних органов (ларингити, езофагити, пульмонити, ректити, циститы, энтероколиты).
ПОСТЛУЧЕВАЯ ЭРИТЕМА НА ЛИЦЕ ПОСЛЕ ОБЛУЧЕНИЯ БАЗАЛИОМЫ
Глоссит при облучении ротовой полости
ФИБРОЗ после облучения рака почки
МЕСТНЫЕ РЕАЦИИ. профилактика • Во время проведения лучевой терапии систематически проводится профилактика местных реакций на коже и слизистых оболочках. • применяют индифферентные жиры или жировые растворы: метилурацилову 10% мазь, мазь этония; • для уменьшения лучевых реакций на слизистых оболочках – косточковое масло, смесь оливковое и облепиховое масла, слизистые отвары, настои лекарственных трав (ромашки, шалфея).
ОБЩИЕ РЕАЦИИ • Проявления общей реакции организма зависят от участка облучения, интегральной поглощенной дозы и ритма облучения. • Проявления общей реакции усиливаются , если в зону облучения попадают органы брюшной полости, малого таза, грудной полости и значительно слабее выраженные при облучении конечностей.
ОБЩИЕ РЕАЦИИ К ним относятся нарушения функций разных органов и систем : • головная боль, • тошнота, • рвота, • тахи- и брадикардия, • гипо- и гипертония), • изменения морфологического состава крови – тромбоцитопения, анемия, лейкопения и др.
изменения морфологического состава крови – анемия
ОБЩИЕ РЕАЦИИ Для профилактики и терапии общих лучевых реакций применяют комплекс средств, которые включают: • гемостимулирующие препараты (при необходимости больным проводят переливание крови, плазмы), • витамины, • антибиотики, • применяют дезинтоксикационную терапию, противовоспалительную терапию, • антигистаминные препараты.
ЛУЧЕВЫЕ ОСЛОЖНЕНИЯ это органические и функциональные изменения органов и тканей, которые нуждаются в специальном лечении
ЛУЧЕВЫЕ ОСЛОЖНЕНИЯ Чаще всего причиной развития лучевых повреждений являются: недостатки в планировании и проведении лучевой терапии, когда подводятся излишне высокие суммарные и разовые очаговые дозы, которые превышают толерантность здоровых тканей.
ЛУЧЕВЫЕ ОСЛОЖНЕНИЯ В зависимости от длительности места времени по возникновения по окончании лучевого окончании лечения лучевые лучевого лечения осложнения делят на лучевые • ранние осложнения делят • поздние на • местные • общие
ЛУЧЕВЫЕ ОСЛОЖНЕНИЯ ранние лучевые осложнения • развиваются на протяжении первых 3 -х месяцев после облучения
ЛУЧЕВЫЕ ОСЛОЖНЕНИЯ поздние лучевые осложнения • те, что возникают позже 3 -х месяцев по окончании лучевого лечения
Мазок крові при гострому монобластному лейкозі
ЛУЧЕВЫЕ ОСЛОЖНЕНИЯ местные лучевые осложнения на коже: • атрофия, • индуративний отек, • лучевая язва, • лучевой рак; на слизистых оболочках : • атрофия, • лучевая язва, • свищи и фистулы в других органах • фиброзы, • язвы, • некрозы, • лучевые раки.
ЛУЧЕВЫЕ ОСЛОЖНЕНИЯ местные лучевые осложнения на коже: • атрофия, • индуративний отек, • лучевая язва, • лучевой рак; на слизистых оболочках : • атрофия, • лучевая язва, • свищи и фистулы в других органах • фиброзы, • язвы, • некрозы, • лучевые раки.
ЛУЧЕВЫЕ ОСЛОЖНЕНИЯ • Общими проявлениями лучевых повреждений являются стойкие изменения морфологического состава крови и хроническая лучевая болезнь. • При выявлении лучевых повреждений лечение больных проводится в специализированных медицинских заведениях.
Пример «Горячей» лучевой язвы Точка А – максимал ьное проявлен ие лучевого поврежде ния; Точка В – граница лучевого поврежде
ЛУЧЕВАЯ ЯЗВА Точка А - максимальное проявление лучевого повреждения; Точка В – видимая граница язвы; Точка С – внешняя граница перифокального компонента; Точка Д – необлученные ткани
Б-ой с лучевой язвой, закончивший спец. лечение 2 – после 3 – после 1 – до окончания МЛТ 1 -го курса МЛТ лечения
МАТЕРИАЛ ДЛЯ КОНТРОЛЯ • Какие патологические состояния относятся к лучевым осложнениям? А) Гиперемия Б) Эпителиит эпидермит , В) Лучевая язва Г) Лучевой фиброз Д) Эзофагит
МАТЕРИАЛ ДЛЯ КОНТРОЛЯ • Какие патологические состояния относятся к лучевым осложнениям? А) Гиперемия Б) Эпителиит эпидермит , В) Лучевая язва Г) Лучевой фиброз Д) Эзофагит
МАТЕРИАЛ ДЛЯ КОНТРОЛЯ • Какие патологические состояния относятся к местным лучевым реакциям? А) Гиперемия Б) Лучевая болезнь В) Лучевая язва Г) Лучевой рак Д) Тромбоцитопения
МАТЕРИАЛ ДЛЯ КОНТРОЛЯ • Какие патологические состояния относятся к местным лучевым реакциям? А) Гиперемия Б) Лучевая болезнь В) Лучевая язва Г) Лучевой рак Д) Тромбоцитопения
МАТЕРИАЛ ДЛЯ КОНТРОЛЯ • Какие патологические состояния относятся к общим лучевым осложнениям? А) Гиперемия Б) Эпителиит эпидермит , В) Лучевая язва Г) Лучевой фиброз Д) Лучевая болезнь

